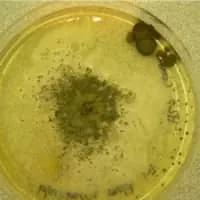

Chaetomium
| Use attributes for filter ! | |
| Class | Sordariomycetes |
|---|---|
| Scientific name | Chaetomium |
| Higher classification | Chaetomiaceae |
| Order | Sordariales |
| Rank | Genus |
| Kingdom | Fungi |
| Date of Reg. | |
| Date of Upd. | |
| ID | 2339960 |
About Chaetomium
Chaetomium is a genus of fungi in the Chaetomiaceae family. It is a dematiaceous mold normally found in soil, air, cellulose and plant debris. According to the Dictionary of the Fungi, there are about 95 species in the widespread genus.